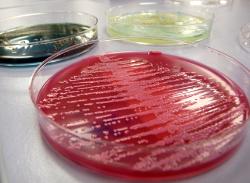
insuficiencia_renal_madrid

Nefrología
Responsables y contacto:
Imagen en alta resolución. Este enlace se abrirá mediante lightbox, puede haber un cambio de contextoLa insuficiencia renal aguda es una grave alteración de las funciones que realizan los riñones y que se produce de forma brusca, poniendo en peligro la vida del paciente.
Imagen en alta resolución. Este enlace se abrirá mediante lightbox, puede haber un cambio de contextoLa insuficiencia renal aguda es una grave alteración de las funciones que realizan los riñones y que se produce de forma brusca, poniendo en peligro la vida del paciente.
Se puede dar por efecto de enfermedades generales que alteran la situación hemodinámica (como sepsis, deshidratación, shock, situaciones postquirúrgicas, politraumatismos); por enfermedad renal primaria de aparición brusca (como la glomerulonefritis aguda). Y, por último, por obstrucción de la vía urinaria (uropatía obstructiva).
El correcto diagnóstico será definitivo para la elección del tratamiento, que va desde un tratamiento médico conservador hasta una terapia renal sustitutiva con técnicas de depuración extrarrenal.
En Hospital Universitario Quirónsalud Pozuelo disponemos de técnicas de hemodiafiltración continua para tratamiento de la insuficiencia renal aguda.
Artículos de
Consulta los últimos artículos en Tu canal de salud.

Área personal de salud: Mi Quirónsalud
Accede a cualquier hora del día para cuidar tu salud y la de los tuyos.
Mi Quirónsalud es tu espacio personal privado y seguro en el que puedes solicitar y gestionar tus citas o consultar tus informes clínicos sin esperas ni desplazamientos.
¡Descúbrelo!






